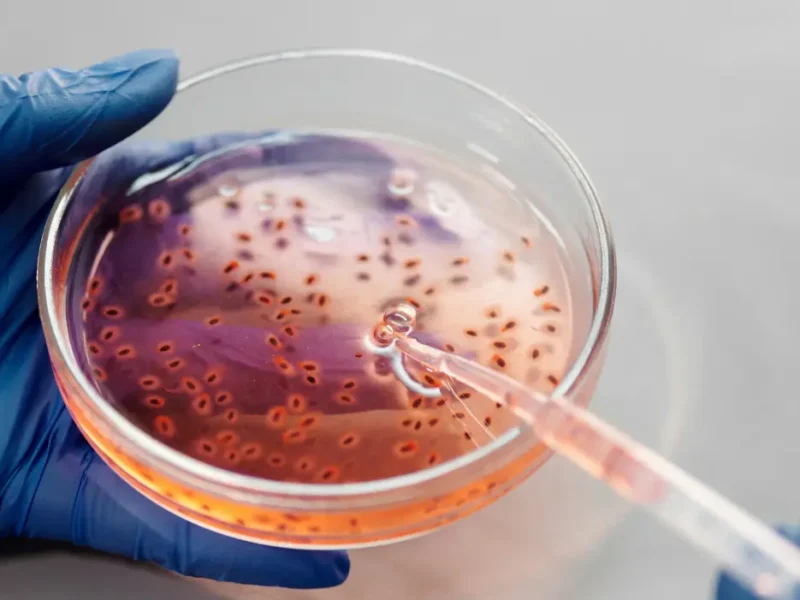

Osteoporosi: le ultime novità scientifiche del 2025 tra terapia farmacologica, dispositivi innovativi e approcci nutrizionali
Nel 2025 la ricerca sull’osteoporosi ha compiuto progressi significativi, con nuove terapie anaboliche, dispositivi medici all’avanguardia e un'attenzione crescente all’immunonutrizione come supporto alla salute ossea...
01 Ottobre, 2025